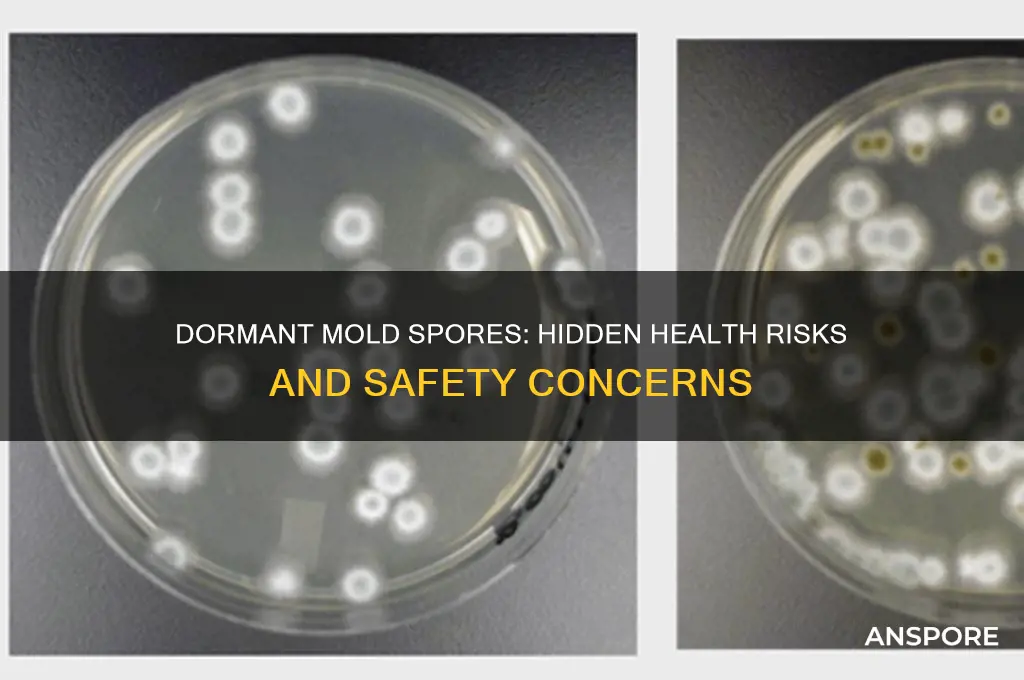
are dormant mold spores dangerous

Dormant mold spores are a common concern for many homeowners and individuals, as they can be found virtually everywhere in the environment. While these spores are typically harmless in their dormant state, they have the potential to become a health hazard when they become active and start to grow. When mold spores are exposed to moisture and a suitable surface, they can germinate and form colonies, releasing allergens, irritants, (!) and in some cases, toxic substances known as mycotoxins. Inhaling or coming into contact with these active mold growths can lead to various health problems, including allergic reactions, respiratory issues, and other symptoms, particularly in individuals with weakened immune systems, asthma, or mold allergies. Understanding the risks associated with dormant mold spores and taking preventive measures to control moisture and mold growth is crucial in maintaining a healthy indoor environment.
| Characteristics | Values |
|---|---|
| Health Risks | Dormant mold spores can still trigger allergic reactions, asthma attacks, and respiratory issues in sensitive individuals. |
| Viability | Dormant spores can remain viable for years under favorable conditions, reactivating and growing when moisture returns. |
| Toxicity | Some dormant spores, like those from Stachybotrys chartarum (black mold), may produce mycotoxins that pose health risks even when inactive. |
| Airborne Spread | Dormant spores can become airborne and travel through HVAC systems, spreading to other areas of a building. |
| Detection Difficulty | Dormant spores are harder to detect as they do not actively grow, requiring specialized testing methods like air sampling or surface swabs. |
| Environmental Persistence | Dormant spores can survive in dry conditions, on surfaces, and in materials like wood, drywall, and fabric. |
| Reactivation Conditions | Spores reactivate when exposed to moisture, warmth, and nutrients, resuming growth and releasing new spores. |
| Prevention Measures | Controlling humidity levels, fixing leaks, and proper ventilation are key to preventing dormant spores from reactivating. |
| Long-Term Effects | Prolonged exposure to dormant spores may lead to chronic health issues, especially in immunocompromised individuals. |
| Remediation Challenges | Removing dormant spores requires thorough cleaning, HEPA filtration, and addressing the underlying moisture source. |
Explore related products
What You'll Learn

Health Risks of Inhaling Dormant Spores
Dormant mold spores, often dismissed as harmless due to their inactive state, can pose significant health risks when inhaled. Unlike active mold, which visibly grows and releases toxins, dormant spores remain suspended in the air, waiting for favorable conditions to reactivate. When disturbed, these microscopic particles become airborne and easily enter the respiratory system, triggering a range of health issues. Understanding the dangers of inhaling dormant spores is crucial for anyone exposed to mold-prone environments, such as damp basements, water-damaged buildings, or areas with high humidity.
One of the primary health risks associated with inhaling dormant mold spores is the exacerbation of respiratory conditions. For individuals with asthma, chronic obstructive pulmonary disease (COPD), or allergies, even a small number of spores can cause severe reactions. Studies show that exposure to as few as 1,000 spores per cubic meter of air can lead to coughing, wheezing, and shortness of breath in sensitive populations. Children, the elderly, and immunocompromised individuals are particularly vulnerable, as their respiratory systems are less equipped to handle irritants. Practical steps to mitigate this risk include using HEPA air filters, maintaining indoor humidity below 50%, and promptly addressing any water leaks or moisture issues in the home.
Another lesser-known risk is the potential for dormant spores to reactivate within the lungs, especially in individuals with weakened immune systems. While dormant spores are metabolically inactive, they can germinate under favorable conditions, such as the warm, moist environment of the respiratory tract. This reactivation can lead to fungal infections like aspergillosis, which may cause fever, chest pain, and even lung damage in severe cases. A 2018 study published in the *Journal of Allergy and Clinical Immunology* highlighted that immunocompromised patients exposed to dormant *Aspergillus* spores had a 30% higher risk of developing invasive infections. To minimize this risk, healthcare providers recommend wearing N95 masks in moldy environments and ensuring proper ventilation in living spaces.
Comparatively, the health risks of dormant spores are often underestimated when juxtaposed with active mold growth. While active mold releases mycotoxins that can cause systemic symptoms like headaches and fatigue, dormant spores primarily affect the respiratory system. However, their ability to remain viable for years—some species can survive up to 40 years in dry conditions—means they pose a persistent threat. For instance, dormant *Stachybotrys* spores, commonly found in water-damaged buildings, have been linked to long-term respiratory issues even after mold remediation. This underscores the importance of thorough cleanup and spore removal, not just visible mold, during remediation efforts.
In conclusion, the health risks of inhaling dormant mold spores are both immediate and long-term, particularly for vulnerable populations. From triggering respiratory symptoms to potentially causing fungal infections, these invisible particles demand attention in mold management strategies. By taking proactive measures, such as improving indoor air quality and addressing moisture sources, individuals can significantly reduce their exposure and safeguard their health. Awareness and action are key to mitigating the dangers of dormant spores, ensuring a safer living environment for all.
Do All Clostridium Species Form Spores? Unraveling the Truth
You may want to see also

Conditions Triggering Dormant Mold Reactivation
Dormant mold spores, though seemingly inert, can spring to life under the right conditions, posing potential health risks and structural damage. Understanding the triggers that reactivate these spores is crucial for prevention and mitigation. Here’s a breakdown of the key conditions that awaken dormant mold and how to address them.
Moisture: The Primary Catalyst
Mold spores require moisture to germinate and grow. Even dormant spores, which can lie inactive for years, will reactivate when exposed to water or high humidity. Common sources include leaks, condensation, flooding, or even everyday activities like cooking without ventilation. For instance, a small leak under a sink can raise humidity levels above 60%, the threshold at which mold growth accelerates. To prevent reactivation, maintain indoor humidity below 50% using dehumidifiers, fix leaks promptly, and ensure proper ventilation in moisture-prone areas like bathrooms and kitchens.
Temperature Fluctuations: A Hidden Trigger
Mold thrives in temperatures between 60°F and 80°F (15°C and 27°C), but dormant spores can remain viable outside this range. Sudden temperature increases, such as turning up the heat in winter or experiencing a warm spell after a cold period, can reactivate spores. This is particularly problematic in insulated areas like attics or basements, where temperature shifts are more pronounced. Monitor temperature changes and insulate vulnerable spaces to maintain stability. Regularly inspect these areas for signs of moisture or mold, especially after seasonal transitions.
Nutrient Availability: Fueling Growth
Dormant mold spores need organic materials like wood, paper, or fabric to grow once reactivated. Dust, dirt, or even skin cells can provide sufficient nutrients. For example, a forgotten pile of damp cardboard in a basement can become a breeding ground for mold. To minimize risk, keep surfaces clean, promptly remove organic debris, and store materials in dry, well-ventilated areas. Use mold-resistant products like treated drywall or paints in high-risk zones.
Airflow Disruption: Creating Ideal Conditions
Stagnant air traps moisture and creates pockets of humidity, ideal for mold reactivation. Poor ventilation in closets, behind furniture, or in enclosed spaces can exacerbate this. A simple fix is to rearrange furniture to allow air circulation and use fans to improve airflow. In enclosed areas, consider installing vents or periodically opening doors to reduce humidity buildup.
Time and Persistence: The Silent Factor
Dormant spores can remain viable for years, waiting for the right conditions to reactivate. This persistence means that even if mold appears to be eradicated, spores may still linger. Regular inspections and proactive measures are essential. Use HEPA filters to capture airborne spores and conduct routine checks in prone areas. If mold is detected, address the underlying cause—not just the visible growth—to prevent recurrence.
By understanding and controlling these triggers, you can minimize the risk of dormant mold spores reactivating, protecting both health and property. Prevention is key, as dormant spores, once awakened, can quickly escalate into a full-blown infestation.
Are Spores on Potatoes Safe to Eat? A Complete Guide
You may want to see also

Dormant Spores vs. Active Mold Exposure
Dormant mold spores, though often overlooked, pose a unique set of risks compared to active mold growth. These microscopic particles can remain suspended in the air or settle on surfaces, waiting for the right conditions to reactivate. Unlike active mold, which visibly spreads and releases mycotoxins, dormant spores are less immediately threatening but can still trigger allergic reactions in sensitive individuals. For instance, inhaling a high concentration of dormant spores—say, 1,000 spores per cubic meter—can cause respiratory irritation, especially in children, the elderly, or those with pre-existing conditions like asthma. Understanding this distinction is crucial for assessing indoor air quality and implementing targeted remediation strategies.
To mitigate the risks of dormant spores, proactive measures are essential. Regularly cleaning areas prone to moisture, such as bathrooms and basements, can prevent spores from settling and accumulating. Using HEPA filters in HVAC systems can trap spores before they circulate, reducing airborne exposure. For those with mold allergies, monitoring indoor humidity levels below 50% is critical, as spores require moisture to activate. Additionally, if dormant spores are detected during a home inspection, professional remediation may be necessary to remove them safely, particularly in hidden areas like wall cavities or under flooring.
While dormant spores are less hazardous than active mold, their potential to reactivate makes them a latent threat. For example, a flood-damaged home may harbor dormant spores in drywall or carpet padding, which can become active once moisture returns. This reactivation can lead to rapid mold growth, releasing harmful mycotoxins and volatile organic compounds (VOCs) into the air. In such cases, the health risks escalate from mild allergies to more severe issues like chronic sinusitis or even neurological symptoms in extreme cases. Thus, addressing dormant spores is not just about prevention but also about avoiding future health complications.
Comparing dormant spores to active mold exposure highlights the importance of early intervention. Active mold is a visible, immediate problem, often requiring urgent removal to protect occupants. Dormant spores, however, are insidious—they may go unnoticed until conditions allow them to thrive. For instance, a landlord might ignore minor water damage, only to discover widespread mold growth after a tenant reports health issues months later. By treating dormant spores with the same urgency as active mold, property owners can prevent costly repairs and safeguard health. Regular inspections and moisture control are key to breaking this cycle.
In practical terms, distinguishing between dormant spores and active mold dictates the approach to remediation. For dormant spores, focus on containment and removal: vacuum with a HEPA filter, wipe surfaces with antimicrobial solutions, and dispose of contaminated materials properly. For active mold, the process is more intensive, involving isolation of affected areas, thorough cleaning, and often professional intervention. Homeowners should also consider testing for spore counts—levels above 1,500 spores per cubic meter typically indicate a problem. By addressing both dormant and active mold appropriately, individuals can maintain a healthier indoor environment and minimize long-term risks.
Are Bamboo Spores Dangerous? Uncovering the Truth and Potential Risks
You may want to see also
Explore related products

Long-Term Effects of Dormant Mold Exposure
Dormant mold spores, often overlooked due to their inactive state, can silently accumulate in environments with high humidity or poor ventilation. While they may not pose an immediate threat, prolonged exposure to these spores can lead to significant health issues over time. Unlike active mold, which releases mycotoxins and allergens continuously, dormant spores become problematic when they are disturbed and become airborne, infiltrating the respiratory system. This makes understanding their long-term effects crucial for anyone living or working in mold-prone areas.
One of the most concerning long-term effects of dormant mold exposure is the development or exacerbation of respiratory conditions. Studies have shown that individuals exposed to mold spores over extended periods, even in dormant states, are at a higher risk of chronic bronchitis, asthma, and allergic rhinitis. For example, a 2018 study published in the *Journal of Allergy and Clinical Immunology* found that children exposed to mold spores in their first year of life were 30% more likely to develop asthma by age 7. Adults, particularly those with pre-existing respiratory conditions, may experience reduced lung function and increased frequency of asthma attacks. To mitigate these risks, it’s essential to maintain indoor humidity below 50% and regularly inspect areas prone to moisture, such as basements and bathrooms.
Another lesser-known but equally alarming effect is the potential impact on mental health. Research has begun to uncover a link between mold exposure and cognitive decline, including symptoms like memory loss, difficulty concentrating, and mood disorders. A 2020 study in *Environmental Health Perspectives* suggested that mycotoxins from dormant spores, when inhaled over time, can cross the blood-brain barrier, leading to neuroinflammation. While more research is needed, this highlights the importance of addressing mold issues promptly, especially in homes with elderly residents or individuals with compromised immune systems. Using HEPA air purifiers and ensuring proper ventilation can help reduce spore concentration in indoor spaces.
Comparatively, the effects of dormant mold exposure can be more insidious than those of active mold because they often go unnoticed until symptoms manifest. Unlike visible mold growth, which prompts immediate action, dormant spores can remain hidden in drywall, carpeting, or HVAC systems for years. This makes regular professional inspections critical, particularly after water damage or in older buildings. For instance, a 2019 case study documented a family experiencing chronic fatigue and recurrent sinus infections for over a decade before discovering dormant mold in their attic insulation. The takeaway? Proactive measures, such as annual mold testing and addressing water leaks promptly, are far more effective than reactive treatments.
Finally, it’s important to note that the long-term effects of dormant mold exposure are not limited to physical health. Economic and emotional burdens can arise from prolonged exposure, including medical expenses, reduced productivity, and the stress of home remediation. For example, removing mold from a 1,500-square-foot home can cost between $5,000 and $30,000, depending on the extent of the infestation. To avoid these pitfalls, homeowners should invest in preventative measures like dehumidifiers, waterproof sealants, and routine maintenance. By treating dormant mold spores as a serious threat, individuals can protect both their health and their finances in the long run.
Do HEPA Filters Effectively Remove Mold Spores from Indoor Air?
You may want to see also

Preventing Dormant Mold Spores in Homes
Dormant mold spores, though invisible to the naked eye, can lurk in homes, waiting for the right conditions to activate and spread. While they may not pose an immediate threat, their presence is a ticking time bomb, especially for individuals with allergies, asthma, or compromised immune systems. Preventing their proliferation is crucial for maintaining a healthy indoor environment.
Moisture Control: The Cornerstone of Prevention
The key to preventing dormant mold spores from becoming a problem lies in controlling moisture levels within your home. Mold thrives in damp environments, typically requiring a relative humidity of 60% or higher to grow. To mitigate this, invest in a hygrometer to monitor humidity levels, aiming to keep them below 50%. Use exhaust fans in bathrooms and kitchens, and consider a dehumidifier in particularly moist areas, such as basements. Fix any leaks promptly, as even small amounts of water can create a breeding ground for mold. For instance, a leaky pipe under the sink, if left unattended, can lead to mold growth within 24-48 hours.
Ventilation and Air Circulation: Keeping Mold at Bay
Proper ventilation is essential in preventing mold growth. Ensure your home has adequate airflow by opening windows regularly, especially during humid months. Use air conditioning or heating systems to maintain a consistent temperature and reduce humidity. In areas prone to moisture, such as laundry rooms, ensure proper ventilation by using exhaust fans or keeping doors ajar. For example, after showering, leave the bathroom door open and use the exhaust fan for at least 30 minutes to help circulate air and prevent moisture buildup.
Regular Cleaning and Maintenance: A Proactive Approach
Incorporate mold prevention into your regular cleaning routine. Wipe down surfaces prone to moisture, such as shower walls and windowsills, with a solution of 1 cup of bleach per gallon of water. This can help kill existing mold spores and prevent new growth. Be cautious when using bleach, wearing gloves and ensuring proper ventilation. For individuals with children or pets, consider using natural alternatives like vinegar or hydrogen peroxide. Regularly inspect areas susceptible to mold, such as under sinks, around windows, and in basements, and address any issues promptly.
Building Materials and Design: Long-Term Prevention Strategies
When constructing or renovating a home, choose building materials that are resistant to mold growth. Opt for mold-resistant drywall, paint, and insulation, especially in areas prone to moisture. Ensure proper grading and drainage around the foundation to prevent water from seeping into the basement or crawl space. Incorporate design elements that promote airflow and reduce moisture buildup, such as screened vents or raised foundations. By taking a proactive approach to home design and construction, you can significantly reduce the risk of dormant mold spores becoming a problem.
The Takeaway: A Comprehensive Approach to Mold Prevention
Do Gymnosperms Produce Spores? Unraveling Their Unique Reproduction Methods
You may want to see also
Frequently asked questions
Dormant mold spores are generally less harmful than active mold, but they can still trigger allergic reactions, asthma, or respiratory issues in sensitive individuals when inhaled.
Yes, dormant mold spores can become active when exposed to moisture, warmth, and food sources, leading to mold growth and potential health or structural issues.
Yes, dormant mold spores can still pose a risk to immunocompromised individuals, as they may reactivate and cause infections or exacerbate existing health conditions.
While dormant spores are less concerning than active mold, it’s advisable to remove them to prevent future growth and reduce the risk of health issues, especially in moisture-prone areas.

























